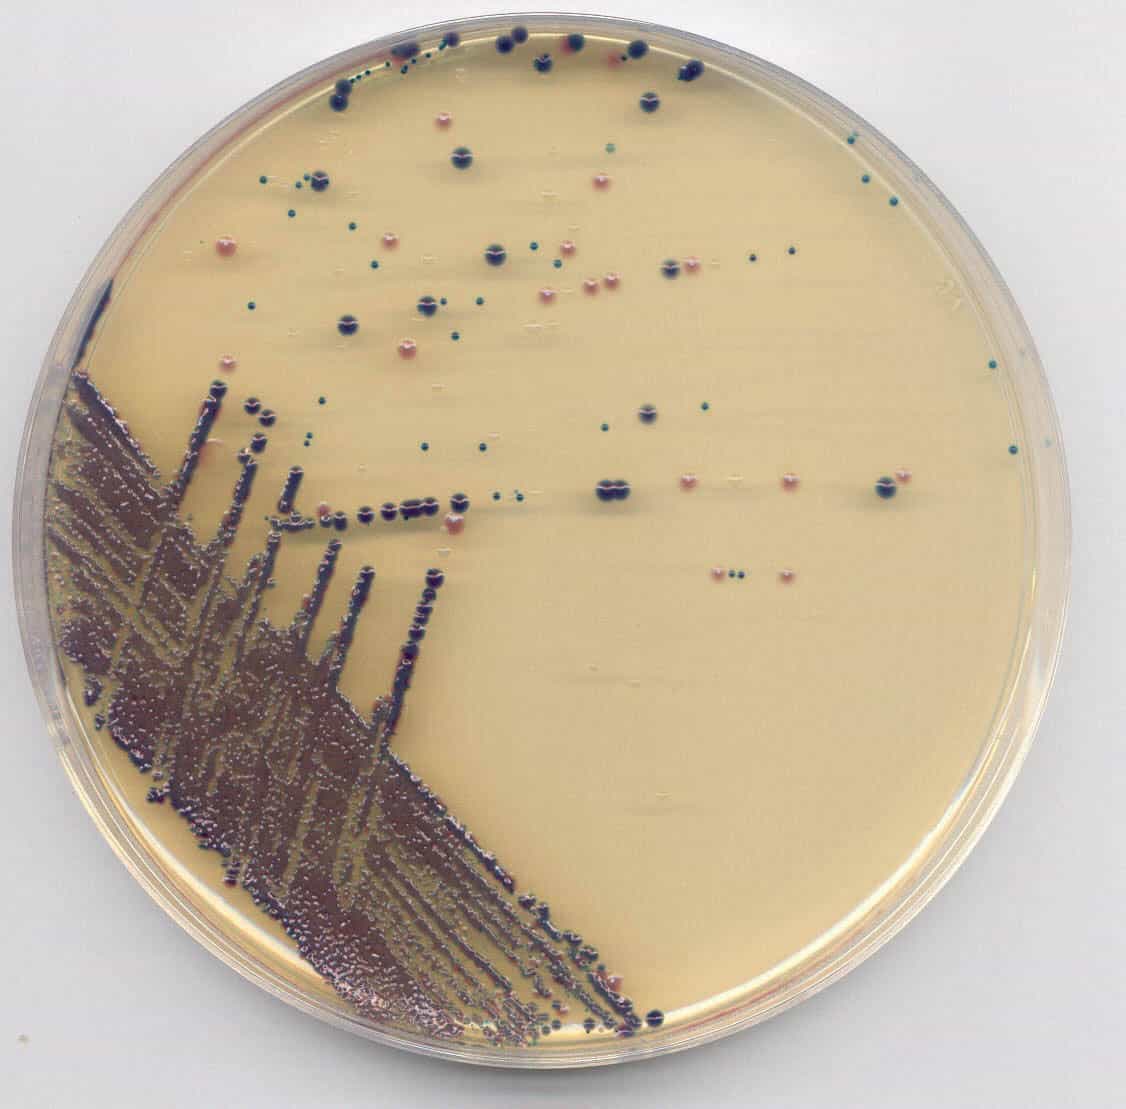

History of the agar plate

From its humble beginnings as simple meat extract to the advanced science of diagnostic media, the agar plate has always been the workhorse of the microbiologist
From its humble beginnings as simple meat extract to the advanced science of diagnostic media, the agar plate has always been the workhorse of the microbiologist
 The origins of Oxoid’s culture media go back to the 19th Century when the science of bacteriology was just beginning. The original parent company, the Liebig Extract of Meat Company (Lemco) was formed in 1865 and manufactured meat infusion extracts under the trade name Lab Lemco. This could conveniently be used in laboratories to grow bacteria, as well as being a popular food product that started as ‘Leibig Company’s Extract of Meat’ which later became Oxo.Early biologists’ generally attempted to grow micro-organisms using the food or sample on which the organism had first been observed – such as Bartolomeo Bizio’s 1832 study of ‘blood spots’ on communion wafers, caused by Serratia marcescens, which used bread as a growth medium1. However, when dealing with non-pigmented organisms and pathogens, Robert Koch found that broths based on fresh beef serum or meat extracts (bouillions) gave the best growth2.
The origins of Oxoid’s culture media go back to the 19th Century when the science of bacteriology was just beginning. The original parent company, the Liebig Extract of Meat Company (Lemco) was formed in 1865 and manufactured meat infusion extracts under the trade name Lab Lemco. This could conveniently be used in laboratories to grow bacteria, as well as being a popular food product that started as ‘Leibig Company’s Extract of Meat’ which later became Oxo.Early biologists’ generally attempted to grow micro-organisms using the food or sample on which the organism had first been observed – such as Bartolomeo Bizio’s 1832 study of ‘blood spots’ on communion wafers, caused by Serratia marcescens, which used bread as a growth medium1. However, when dealing with non-pigmented organisms and pathogens, Robert Koch found that broths based on fresh beef serum or meat extracts (bouillions) gave the best growth2.
Solid Media In 1881 Robert Koch demonstrated a new technique at the International Medical Congress in London. Koch had recognised the difficulties of using broth media for isolation of pure cultures and had looked for solid media alternatives. He evaluated media such as coagulated egg albumen, starch paste and an aseptically cut slice of a potato (as used by the German biologist Schroeter), but then moved to a meat extract with added gelatin. The resulting ‘nutrient gelatin’ was poured onto flat glass plates which were inoculated and placed under a bell jar. This new plate technique could be used both to isolate pure cultures of bacteria and to sub-culture them either onto fresh plates or nutrient gelatin slopes in cotton-wool plugged tubes3.
Although nutrient gelatin was a major advance, gelatin had two major disadvantages as a gelling agent: • It turned from a gel to a liquid at 25oC – preventing plates from being incubated at higher temperatures. • It was hydrolysed by gelitinase – an enzyme produced by most proteolytic organisms.
It was in 1882 that Fannie Hesse suggested replacing gelatin with agar4. Fannie, wife of Walther Hesse, was working in Koch’s laboratory as her husband’s technician and had previously used agar to prepare fruit jellies after hearing about its gelling properties from friends. Agar is a polysaccharide derived from red seaweeds, and proved to be a superior gelling agent. Agar has remarkable physical properties: it melts when heated to around 85oC, and yet when cooled doesn’t gel until 34-42oC. Agar is also clearer than gelatin and it resists digestion by bacterial enzymes. The use of agar allows the creation of a medium that can be inoculated at 40oC in its cooled molten state and yet incubated at 60oC without melting.
Although meat extract is a valuable source of many growth factors for bacteria it lacks sufficient amino-nitrogen to allow optimal growth of a range micro-organisms. In 1884 Fredrick Loeffler added peptone and salt to Koch’s basic meat extract formulation5. The peptone he used was an enzymatic digest of meat, produced in the 19th Century as a pharmaceutical product, usually prescribed for nutritional disorders. This peptone added amino-nitrogen, while the salt raised the osmolarity of the medium.
In 1887 Julius Richard Petri, another worker in Koch's laboratory, modified the flat glass plate and produced a new type of culture dish for media4. The Petri dish was designed with an overhanging lid to keep contaminants out.
By the 1890s the culture media we know today, with Petri dishes, peptones and agar, were developed. However, many of the earlier methods continued to be used - as shown by this plate from the 1896 Lehmann’s Medicin Handatlanten6 which shows the appearance of Bacterium pyocyaneum on a variety of media types:
Plate taken from Lehmann’s 1896 Medicin Handatlanten

Selective Media Media, however, were still not discriminatory – they grew whatever was inoculated onto them with only colony morphology, staining and microscopy to help differentiate organisms. The first step towards diagnostic media was in 1888 when Martinus Beijerinck developed an elective medium (one which uses nutritional requirements to limit what can grow on a plate). Beijerinck wanted to isolate the root nodule bacterium Rhizobium, which is capable of fixing atmospheric nitrogen. To do this he designed a medium containing no nitrogenous compounds. This inhibited the growth of non-nitrogen fixing organisms and produced a pure culture of Rhizobium. Beijerinck went on to use another elective medium, based on the ability to use CO2 as a carbon source under anaerobic conditions, to isolate the first pure culture of sulphur-oxidizing bacterium Thiobacillus denitrificans in 19047.
Although chemicals, such as dyes, had been known to have antimicrobial effects since 1885, (when Paul Ehrlich published work on the inhibitory effect of arsenic compounds on syphilis8) they were not incorporated into media formulations until the first selective media were developed in the 1900s.
Early selective agents tended to be chemicals and dyes used for other purposes within the laboratory that were found, by chance, to have the ability to inhibit certain micro-organisms: • 1905: MacConkey used bile salts to select for lactose fermenting bacteria in faecal samples9. The level of conjugation in the bile salts determines its selectivity profile: conjugated bile salts are less inhibitory and allow the growth of staphylococci and enterococci; while more disassociated salts such as desoxycholate are much more selective, only allowing growth of Enterobacteriacae. [inset pic 3: MacConkey Agar] • 1912: Churchman showed that derivatives of triphenylmethane such as gentian violet and brilliant green dyes were inhibitory to bacteria, particularly Gram positives; and crystal violet causes some inhibition of fungi4. • 1923: Muller described a medium using iodine and sodium thiosulphate which react together to form tetrathionate10. The selectivity of tetrathionate depends on whether or not an organism possesses the enzyme tetrathionase. Salmonellae and Proteus species possess the enzyme, so can grow in the presence of tetrathionate.
Fleming, Florey and Chain were awarded the Nobel Prize in 1945 for the development of penicillin, but it wasn’t until the 1960s that antibiotics were used in culture media as selective agents. Thayer-Martin’s publication in 196411, detailing a formulation for the isolation of Neisseria gonorrhoeae and N. meningitides, using a mixture of vancomycin, colistin and trimethoprim, was probably not the first to use antibiotics, but is one of the most widely documented early examples of antibiotics being used in a selective medium.
Diagnostic Media The diagnostic value of haemolytic reactions wasn’t recognised until It wasn’t until 1919 when James Brown used a blood agar to study the haemolysis reactions of the genus Streptococcus and was able to differentiate alpha, beta and gamma haemolysis12.
So has much changed in the 80 years since the Oxoid name was first used?
The science of microbiology has certainly come a long way with the development of immunological and molecular methods but have culture media changed very much? Certainly many of the basic ingredients come from the same sources as those used by Koch, but the science behind the products has definitely moved on.
Peptones – Lab Lemco, a beef extract based on that originally sold by Leibig’s Extract of Meat Co., is still available today, and Oxoid continue to manufacture peptones from meat (such as liver, heart and veal), milk and vegetable sources in their Basingstoke production facility. Peptones can be hydrolysed using either acid or enzymes, and control of the production processes allows Oxoid to develop new peptones which give optimal growth of specific organisms. The quality of peptones is also tightly controlled with limits on peptone manufacture and quality control specifications for parameters such as the residual moisture, ash, amino and total nitrogen, phosphates, salt, pH, metal ion content, as well as microbiological tests.
But that isn’t to say peptone development hasn’t moved on – Oxoid has recognised the changes in the market, especially pharmaceutical applications where products with components of animal origin are becoming less desirable due to regulatory pressure. Oxoid have developed a range of Veggietones – vegetable based peptones made from raw materials such as pea and fungal proteins that are digested using bacterial and fungal enzymes – all of which are guaranteed to be completely animal free.
Agar – agar is still produced from seaweed, but now we understand much more about how to process the weed to get agars with different characteristics – for example with a low/high temperature gelling or low syneresis (moisture loss). It is critical that media have constant gel strength as the effect on colony morphology can be dramatic. High gel strength media will grow small colonies because the flow of nutrients and removal of toxins is reduced. Low gel strength media will allow the growth of larger colonies, but can be difficult to streak.
Blood – Fresh blood is defibrinated, to remove the clotting factors and variation between batches is minimised by adjusting the packed cell volume, sterility tests are also performed. To ensure the best possible haemolytic reactions, Oxoid prepare their ready-to-use blood plates using an in-line blood addition process and batches of blood that have often been drawn less than 48 hours previously.
Not only has Oxoid defined the science behind many of the traditional ingredients, but they have also introduced many new formulations. In 1930 Levine and Schoenlein13 listed 2,543 published culture media formulations and, although many thousands have been published since, there are probably less than 1000 which are in regular day-to-day use. These tend to be formulations that have been refined over time with the addition of more complex selective or diagnostic ingredients, for example, chromogens.
Food Media Much of the early microbiology had a clinical focus – but the food industry face different challenges. Theirs is not so much a question of identification of an unknown organism, but one of developing specialised methods that can indicate the presence of pathogens even at a level of one organism in 25 g of food. These methods must also detect stressed and injured cells which are sensitive to most selective agents. This requirement for recovery of low levels of stressed pathogens means that most methods are based on pre-enrichment and selective enrichment broths which are used to increase the numbers of target organisms before plating.
Emerging Pathogens New organisms, also present new challenges and require new isolation methods. For example, in 1977 Joseph McDade and Charles C. Shepard identified Legionella pneumophilia as the pathogen which caused Legionnaires disease14– this required the development of new media both for clinical and water testing applications; in 1983 Barry Marshall demonstrated that isolates from gastric and duodenal ulcers all contained a Campylobacter-like organism later called Helicobacter pylori15; as recently as 2002, the first Vancomycin Resistant Staphylococcus aureus was found in Michigan and in 2004 Oxoid launched one of the first chromogenic media to specifically detect the emerging pathogen Enterobacter sakazakii from infant formula milk.
In the past, media were developed through empirical experiments – now they can be designed using in-depth knowledge of both the biochemistry of the target organism and the raw materials. Oxoid control every step in the product chain, from the raw materials to the prepared medium which allows us to develop and produce the high quality media required by microbiology laboratories today.
By Alison Smith, Marketing Manager, Oxoid.
References 1. Bizo, B. (1832) Biblioteca Ital. di. Lett. Sci ed. Arti. 30. 275. 2. Koch, R. (1876) Untersuchungen ueber Bakterien V. Die Aetiologie der Milzbrand-Krankheit, begruendent auf die Entwicklungsgeschichte des Bacillus Anthracis. Beitr. z. Biol. D. Pflanzen 2: 277-310. In Milestones in Microbiology: 1556 to 1940, translated and edited by Thomas D. Brock, ASM Press. 1998, p89 3. Koch, R. (1881) Zur Untersuchung von pathogenen Organismen. Mitth. a. d. Kaiserl. Gesundheitsampte 1: 1-48. Cited in Milestones in Microbiology: 1556 to 1940, translated and edited by Thomas D. Brock, ASM Press. 1998, p101 4. Bridsen, E. (1994) The Development, manufacture and control of microbiological culture media. Published by Oxoid, Basingstoke UK 5. Loeffler, F. (1884) Mittheil. Kaiserl. Gesunheitsante. 2. cited in Brock, T. (1998) Robert Koch: a life in medicine and bacteriology. Science Technical Publications. Madison, WI, USA 6. Lehmann, K. B. and Neumann, R. (1896) Lehmann’s Medicin Handatlanten Band X. Published by J.F. Lehmann Munich 7. Beijerinck, M. (1904) Phenomenes de reduction produits par les microbes. Arch. Neerl. (Section 2) 9: 131-157. 8. Ehrlich, P. (1885) Das Sauerstoff-Bedurfniss des Organismus, eine farbanalytische Studie. Hirschwald, Berlin. 9. MacConkey, A. (1905) Lactose-fermenting bacteria in faeces. J. Hyg., 8; 333-379. 10. Muller, L. (1923) Un noveau milieu d’enrichissement pour la recherché du bacilli typique et des paptyphiques. Compte. Rend. Séance. Soc. Biol. Filiales. 89. 433-437 11. Thayer, J.D., a. Martin, J.E., Jr. (1964) A selective medium for the cultivation of N. gonnorrhoeae and N. meningitidis. - Publ. Health Rep., 79; 49-57 12. Brown, J.H. (1919) The use of blood agar for the study of streptococci. Rockefeller Institute for Medical Research Monograph No.9. The Rockefeler Institute for Medical Research, New York. 13. Levine, M. and Schoenlein, H. W. (1930) A Complilation of culture media. Williams and Williams, Baltimore USA 14. McDade, J. E., Sheperd, C. C., Fraser, D. W., Tsai, T. R., Redus, M. A., Dowdle, W. R. and Laboratory Investigation Team (1977) Legionaire's disease: Isolation of a bacterium and demonstration of its role in other respiratory disease. N. Engl. J. Med. 297: 1197-1203. 15. Warren, J. R., and Marshall, B. (1983) Unidentified curved bacilli on gastric epithelium in active chronic gastritis. Lancet 1: 1273.




